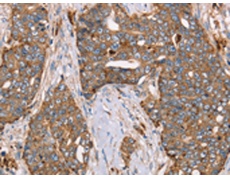
一抗

Background:
The protein encoded by this gene is a lysosomal enzyme involved in the degradation of fucose-containing glycoproteins and glycolipids. Mutations in this gene are associated with fucosidosis (FUCA1D), which is an autosomal recessive lysosomal storage disease. A pseudogene of this locus is present on chr 2.
Applications:
ELISA, WB, IHC
Name of antibody:
FUCA1
Immunogen:
Fusion protein of human FUCA1
Full name:
fucosidase, alpha-L- 1, tissuep
Synonyms:
FUCA
SwissProt:
P04066
ELISA Recommended dilution:
2000-5000
IHC positive control:
Human cervical cancer and Human lung cancer
IHC Recommend dilution:
50-200
WB Predicted band size:
54 kDa
WB Positive control:
Human placenta tissue
WB Recommended dilution:
500-2000


 購(gòu)物車
購(gòu)物車 幫助
幫助
 021-54845833/15800441009
021-54845833/15800441009